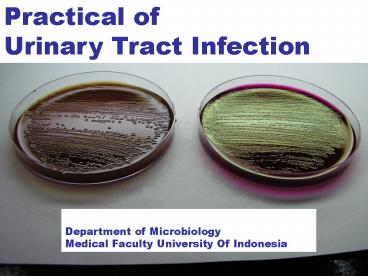

STERILE URINE CONTAINER PowerPoint PPT Presentation
1 / 43
Title: STERILE URINE CONTAINER
1
Practical of Urinary Tract Infection
Department of Microbiology Medical Faculty
University Of Indonesia
2
- Important aspects of Microbiologic
- Examination of UTI
- Specimen collection and handling
- - Specimen processing and culture
- - Interpretation of microbiology
- laboratory result
3
Microbiology of Community-Acquired Urinary Tract
Infection
Dysuria-Pyuria Sydrome in Females
Children Adults
More frequent . Escherichia coli . Escherichia coli . Staphylococus saprophyticus (young, sexually active patient)
Less Frequent . Other Enterobacteriaceae . Enterococci . Streptococcus agalactiae . Other Enterobacteriaceae . Enterococci
Other Community-Acquired Infection
Children Adults
More frequent . Escherichia coli . Escherichia coli
Less Frequent . Other Enterobacteriaceae . Enterococci . Other Enterobacteriaceae . Enterococci
4
Microbiology of Nosocomial Acquired Urinary Tract
Infection in Children or Adult
Catheter-Associated Short-Term (lt 30 d)
Catheterization
More frequent . Escherichia coli
Less Frequent . Other Enterobacteriaceae . Pseudomonas Spp. . Staphylococcus epidermidis
Catheter-Associated Long-Term (gt 30 d)
Catheterization
More frequent . Providencia stuartii . Pseudomonas Spp. . Escherichia coli . Other Enterobacteriaceae
Less Frequent . Staphylococcus epidermidis
5
(No Transcript)
6
(No Transcript)
7
(No Transcript)
8
The urinary catheter Urine specimens for
laboratory investigations can be collected from
catheterized patients as shown (left). The second
port is for putting fluids into the bladder
(right). Urine from the drainage bag should not
be tested because it may have been standing for
several hours.
9
(No Transcript)
10
Sampling Port
Urine collection can be performed without
needle Avoidance of needle stick injury
11
(No Transcript)
12
TRANSPORT MEDIA
Urine specimen is best collected Soon after a
patient wakes when Organisms have had the
opportunity to multiply over several hours.
Urine container criteria Sterile, dry,
wide-necked, leak proof
13
Laboratory examination of urine
Quantitative (Colony counts)
a urine sample is streaked on surface of Blood
Agar plate ( for control) and medium Endo agar /
Mc Conkey agar with a special loop calibrated to
deliver a known volume.
1 2 3 4
Over night incubation
Isolation of colonies,Biochemical tests, Drug
susceptibility test,
Over night incubation
RESULT
Urinary Tract infection Module05 ..
14
Area for colony count
Blood Agar
15
1
Blood Agar
ENDO Agar
16
2
Blood Agar
ENDO Agar
17
3
Blood Agar
ENDO Agar
18
4
Blood Agar
ENDO Agar
19
INTERPRETATION OF COLONY COUNTS
Score Number of colonies Number of bacterial per ml Diagnostic significance
lt 1 50 5.000
1 100 10.000
gt 1 150 15.000
2 200 20.000
gt 2 250 25.000
3 300 30.000
gt 3 500 50.000
4 1000 100.000
gt 4 gt 1000 gt 100.000 Significant bacteriuria
Urinary Tract infection Module05 ..
20
BIOCHEMICAL TEST
Carbohydrate fermentation
Urinary Tract infection Module05 ..
21
Commercially identification
The API 20Etm (produced by Biomerieux) system
for bacteria such as coliform (ONPG
orthonitrophenyl- ?-D-galactopyramoside VP
Voges-Proskauer)
22
- Three API 20E strips
- Immediately after inoculation
- After 24 hours incubation
- That in ( b) after addition of reagents to
certain wells. - The organisms here is Escherichia coli. Here the
first carbohydrate well (glucose) - is also used for the nitrate reduction test
23
Antibiotic susceptibility tests
- Disc Method
- By using Disc which contain antibiotic
- Diameter of Inhibition zone
- Bacterial growth show a response to antibiotic
(NCCLS/CLSI standar) - Density standard Mc Farland 0,5
24
Disc susceptibility test
Using wire loop or Dacron-tipped swab, touch the tops of 4 to 5 bacterial colonies of the same morphology on an agar plate culture. Swab the surface of the plate three times, rotating the plate 60 0 each time.
Transfer the bacteria to a tube containing 4 to 5 mL of Brain Heart Infusion broth or NaCl. Allow 3 to 5 minutes. Using a forceps or multidisk dispenser plate antibiotic impregnated disk on surface of the agar.
Match the density of the bacterial suspension to the 0,5 Mc. Farland density standard. Tamp the disks down firmly onto the surface of the agar. Incubate at 35 0 C for 24 hours.
Insert a cotton-tipped swab into the suspension, the swab firmly against the wall of tube to express excess fluid and streak the surface of dried Mueller-Hinton agar plate. After overnight incubation, use a ruler or caliper to measure the diameter of incubation zones.
Urinary Tract System Module05 ..
25
(No Transcript)
26
Gentamisin (CN) 12 - 15 Chloramphenicol (C)
12 - 18 Penicilin (P) 28 - 29 R
(Resisten) I (Intermediet) S (Sensitif)
P
C
C
P
Staphylococcus aureus
CN
CN
27
- Tube method
- One set of antibiotic dilution in liquid medium
penipisan antibiotik dalam perbenihan cair,
kemudian ditanami bakteri uji - Sensitivity are count by observation where the
bacteria still growth in lowest antibiotic
concentration (MIC)
28
MIC bakteri Escherichia coli 2 ?g
29
E-test strip
30
The common organisms that can cause UTI And
antibiotics to use in treatment
31
Blood agar
- An enriched medium, especially for culturing
fastidious microorganism and observed the
hemolytic reaction
32
Endo C agar cat. No. 4044
Selective culture medium for detection and
isolation Of fecal Escherichia coli and
coliform bacteria in Various material according
to ENDO
Sodium sulfide anf fuchsin inhibit the growth of
Gram positive bacteria. E. coli and coliform
bacteria metabolize lactose with the production
of aldehyde and acid. The aldehyde liberates
fuchsin from the fuchsin-sulfide compound, the
fuchsin then colors the colonies red. E. coli
will giving the permanent greenish metallic sheen
(Fuchsin sheen)
33
MacConkey Agar
A differential medium for detection, isolation
and enumeration of coliform and intestinal
pathogen in water, dairy product and biological
specimens. This agar is particularly
recommended for the cultivation of pathogens
which may be present in a variety of specimens
such as urine, faeces and wound swabs.
MacConkey agar should be used in parallel with
other selective indicator media such as
Desoxycholate Citrate Agar, Bismuth sulphite
agar, Briliant Green Agar and Brilliant Green
bile broth, and non selective medium such as
Blood Agar.
34
NOVOBIOCIN TEST
- This test using for differentiated between
Staphylococcus - epidermidis and Staphylococcus saprophyticus from
- Urine specimens.
- A. Staphylococcus epidermidis (sensitive-Novobioci
n), occasionally cause of urinary infection in
hospital, sometimes associated with
catheterization. - B. Staphylococcus saprophyticus
(resistant-Novobiocin), - it causes cystitis in young women patients in
general - practice beside Escherichia coli
Urinary Tract System Module05 ..
35
(No Transcript)
36
C.L.E.D Medium (Cystine-Lactose-Electrolyte
Deficient)
This medium recommended for urinary bacteriology,
supporting the growth of all urinary pathogens.
The present of important contaminants such as
diphtheroids, lactobacilli and micrococci is also
clearly elicited giving indicate and indication
of the degree of contamination. This medium
prevent the swarming phenomenon by having the low
electrolyte content. Discrete colonies of
motile and non motile bacteria may thus be
urinary bacteriology where motile species,
notably proteus spp. may be present a problem in
identifying the species responsible to UTI.
37
Proteus
- This species causes urinary infection, especially
following - catheterization or cystoscopy.
- Mostly Proteus strains produce a characteristic
swarming growth - over the surface of blood agar and several other
culture media. - Proteus culture have a distinctive smell.
- In laboratory C.L.E.D medium (electrolyte
deficient) provide for - plate culture of urinary organisms for prevents
the swarming - phenomenon
- Proteus spp. posses urease which produces
ammonia in - the urine. This raises the the pH and causes
precipitation - of phosphate crystals, leading to stone formation.
Urinary Tract System Module05 ..
38
(No Transcript)
39
(No Transcript)
40
Pseudomonas
- Pseudomonas aeruginosa
- This species causes urinary infection, usually
following - catheterization or associated with chronic
urinary - infections.
- This species is usually resistant to many
antibiotics - and is particularly associated with recurrent
urinary - tract infection in hospital patients.
Urinary Tract System Module05 ..
41
(No Transcript)
42
(No Transcript)
43
Agar Endo